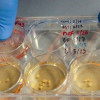

Рекрутинг, військова частина чи «Армія+»: у Міноборони пояснили, як можна повернутися із СЗЧ
Сьогодні 23:00
Сьогодні 23:00
На Любешівщині попрощалися з Героєм Василем Душенком
Сьогодні 22:01
Сьогодні 22:01
На Волині повідомили про підозру екслісничому, який організував незаконну вирубку понад сотні дерев
Сьогодні 20:26
Сьогодні 20:26

.jpg)











